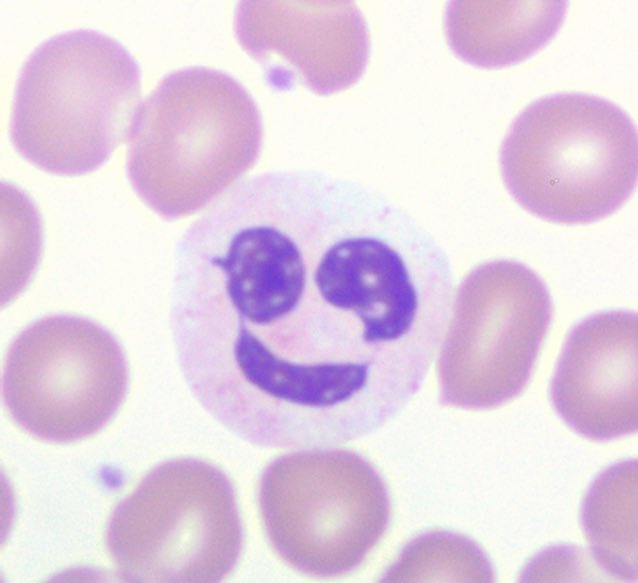
cd45dim's tweet image. Finally at the bottom of a big pile of marrows, just in time for a little vacation!  Current mood:

Eric Carlsen
@cd45dim
Duke hematopathology. Has a favorite lymphoma (doesn’t everybody?). Diagnostician, teacher, and proud papa. This is Twitter, not a doctor’s office.
Bunları beğenebilirsin
I was just invited to be the reviewer for a paper I authored 😂

Unexpected MYC::DMD translocation after transformation of follicular lymphoma with IGH::BCL2 and IGH::MYC onlinelibrary.wiley.com/doi/10.1111/bj… #lymsm

The Hematopathology Fellowship at @UPMCPath offers a robust exposure to many consultation and in-house cases with the mentorship of nationally and internationally recognized experts. Numerous research and teaching opportunities are available. Many more reasons are listed below.


Columbine High School Heritage High School Deming Middle School Fort Gibson Middle School Buell Elementary School Lake Worth Middle School University of Arkansas Junipero Serra High School Santana High School Bishop Neumann High School Pacific Lutheran University
It’s rough, being a pathologist that can’t reliably type “unremarkable”. Unreamrkable. Unremakrable. …NORMAL!!!
There’s just not enough clicks, username/password prompts, and downloads to access Epic. What were they thinking?
#Hematology Lymph node excisions provide more precise #lymphoma diagnoses than core biopsies: a French Lymphopath network survey | @BloodJournal | American Society of Hematology @ASH_hematology #lymsm #hemepath ashpublications.org/blood/article/…
Ever wondered, in a case with 4/8 criteria for HLH,with BM showing fewer phagocytic histios, how many are needed to qualify for 5th criteria? This paper saved my day! 1 engulfed gran, 4 engulfed nrbcs/1000 cells or one with multiple nucleated cells is highly associated with HLH.

CD3/CD20 dual stain for the win! CD20+ T-cell lymphoma. Will try to take some convincing images if anyone wants to see. …does anyone want to see?
“You’ve heard of elf on a shelf, now get ready for…” why am I so terrible at these? What mutation causes rhyme recognition deficiency? Have I devolved into an organism that only engages in neurotransmission when shown images that are H&E or WG-stained?
Always enjoy life and take a Cellfie

Finally at the bottom of a big pile of marrows, just in time for a little vacation! Current mood:
“How do I avoid heme pitfalls?” Read books that discuss differential diagnosis at the end of each section and mine journals that still publish images! IJLH, J Hematopathol, and Blood’s Blood Work can really broaden your horizons. pubmed.ncbi.nlm.nih.gov/35811089/
Monoclonal antibody interference in SPEP and immunofixation is an under-recognized and growing diagnostic dilemma. Take a look at our new paper to see electrophoretic patterns for some of the anti-COVID-19 mAbs. More to come! academic.oup.com/jalm/advance-a…
Best of luck to pathology applicants this year #PathTwitter #PathMatch2023 #ERAS be reassured there are tons of great programs, even if your #1 doesn’t work out. Ask lots of questions and assess a program’s commitment to resident training and trainee community before ranking
@UPMCPath is very grateful to Dr. Steven Swerdlow for his tremendous contribution to patient care, resident and fellow education, and the field of Hematopathology globally. This is one of his last times signing out with trainees before his retirement. @pranavp01 #PathTwitter 🙏

United States Trendler
- 1. Bill Belichick N/A
- 2. Hall of Famer N/A
- 3. Bill Polian N/A
- 4. Brady N/A
- 5. Davis Webb N/A
- 6. HOFer N/A
- 7. Pro Football Hall of Fame N/A
- 8. Spygate N/A
- 9. Aaron Glenn N/A
- 10. Holocaust N/A
- 11. Joe Lombardi N/A
- 12. Shams N/A
- 13. #Budweiser150 N/A
- 14. NFL HOF N/A
- 15. Deflategate N/A
- 16. NFL Hall of Fame N/A
- 17. Iowa N/A
- 18. Senior Bowl N/A
- 19. Philip Glass N/A
- 20. #ValentinoSpeculaMundi N/A
Bunları beğenebilirsin
-
 Dana Martin, MD
Dana Martin, MD
@Dana_E_Martin -
 Prashant Tembhare
Prashant Tembhare
@PrashantTembha1 -
 Jonathan He
Jonathan He
@HoustonArsenal -
 Stephen Simalchik
Stephen Simalchik
@SSimalchik -
 Sehgal Path Lab
Sehgal Path Lab
@SehgalPathLab -
 Carey August
Carey August
@CareyAugust1 -
 Mina L Xu
Mina L Xu
@MinaXu7 -
 Parnaz Danesh
Parnaz Danesh
@Paeanox -
 Gaurav Chatterjee
Gaurav Chatterjee
@Gaurav_C42 -
 Vida Ehyaee
Vida Ehyaee
@VDermida -
 Peng Ji
Peng Ji
@PengJi_lab -
 Mayur
Mayur
@mpfrommp -
 Frida Rosenblum
Frida Rosenblum
@FridaRosenblum
Something went wrong.
Something went wrong.









































































































